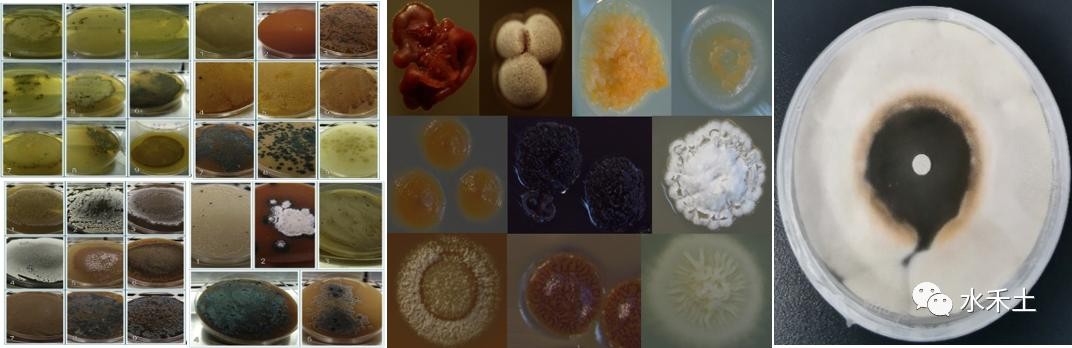

烟台水禾土生物科技有限公司通过省博士后创新实践基地备案
烟台水禾土生物科技有限公司通过省博士后创新实践基地备案
大小新闻客户端6月29日讯(YMG全媒体记者 信召红 通讯员 孙妹)2022年6月10日,按照《山东省博士后创新实践基地管理办法》有关要求,经单位申报、区市审核、市人力资源社会保障部门进行复核和实地考察等程序,烟台水禾土生物科技有限公司通过山东省博士后创新实践基地备案。

博士后创新实践基地是汇聚高端人才的重要平台,旨在发挥博士后科研流动站的人才技术优势,加速科技成果转化。此次通过山东省博士后创新实践基地备案,有利于加强公司与博士后科研流动站的合作,联合培养博士后人才,对公司深入拓宽高层次人才培养途径、深化产学研合作、推动技术创新具有重要意义。
烟台水禾土生物科技有限公司成立于2016年9月,注册资本1250万元。公司位于烟台高新区,占地45亩,是专业从事植物免疫、生态修复领域生物技术与产品的研发生产,致力植物营养与健康的高新技术企业,是国家农药定点生产企业。2021年被评为山东省瞪羚企业、专精特新企业。

公司研发生产大楼


生产车间



研发实验室

仪器设备(部分)
海岸带农用微生物菌种资源库

责编:李志娟
-

- 徐海学院新校区即将惊艳亮相,速度惊人!
-
2026-04-11 06:08:28
-

- 头像来啦!一家三口,一家四口,全家福漫画头像,萌娃头像
-
2026-04-11 06:06:14
-

- 手写常用春联50幅带横批,贴近生活,寓意深远,富有美好的祝愿
-
2026-04-10 12:38:08
-

- 它究竟是好枪还是垃圾?毁誉参半的解放军第一款无托轻机枪95式
-
2026-04-10 12:35:53
-

- 花生日记涉嫌传销被罚没7456万元,明年还要在美上市
-
2026-04-10 12:33:39
-

- 盒马调整薪酬福利、员工转签第三方,降本增效背后加速低价化
-
2026-04-10 12:31:25
-

- 西安公寓项目最强盘点!10盘首付30万内可拿下,曲江有俩
-
2026-04-10 12:29:10
-

- 孙颖莎世界排名第1,王曼昱第2,陈梦降至第4,早田希娜第5
-
2026-04-10 12:26:56
-

- 人工智能潮流下的就业狂潮:AI专业人才的璀璨前景
-
2026-04-10 12:24:42
-

- 北京家暴致死案:26岁新娘婚后十个月被虐死,丈夫获刑6年6个月
-
2026-04-10 12:22:27
-

- 80年前的迪士尼动画长片《幻想曲》,论动画和音乐的魅力
-
2026-04-10 12:20:13
-

- 80道家常蒸菜,营养丰富,老少皆宜~
-
2026-04-10 12:17:59
-

- “冷艳美人”张京,放弃北大、清华,成外交翻译,让美方笑容僵持
-
2026-04-09 16:02:03
-

- 深入解析摩羯座的独特特质与魅力:你对他们了解多少?
-
2026-04-09 15:59:48
-

- 深海掠食者:对人类造成最致命伤害的“箱形水母”
-
2026-04-09 15:57:34
-

- 法律科普丨从民法典的角度来看,“父债子偿”是否合法?
-
2026-04-09 15:55:19
-

- 最高种姓“婆罗门”在印度有多神圣?终身有特权,时刻被军队守护
-
2026-04-09 15:53:05
-

- 请留意别错过!陆续发布2024年艺术统考报名时间、统考时间
-
2026-04-09 15:50:50
-

- 宁城县八里罕酒厂“宁城老窖”的那些事,八里罕名气挺大
-
2026-04-09 15:48:36
-

- “南大碎尸案”受害者家属撤诉原因 家属为什么突然撤诉?“南大碎尸案”详情
-
2026-04-09 15:46:21



 欧美娱乐圈的殿堂级女演员安姨Julia Ann
欧美娱乐圈的殿堂级女演员安姨Julia Ann 中国历代皇帝生平事迹 (9)汉宣帝——刘询
中国历代皇帝生平事迹 (9)汉宣帝——刘询